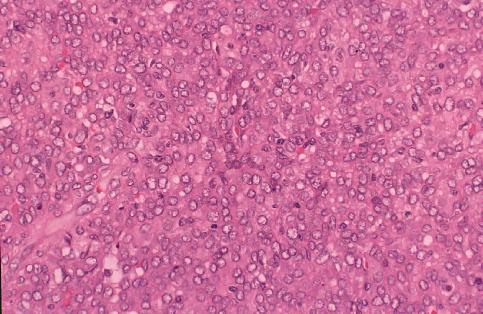

1. Hasegawa, A. and Iwasaki, T.: Rhomboid secretion granules in a juxtaglomerular cell tumour of the kidney. Br J Urol, 79:296-297, 1997.
2. Hasegawa, A.: Juxtaglomerular cell tumor of the kidney: A case report with electron microscopic and flow cytometric investigation. Ultrastructural Pathology (Taylor & Francis) 21:201-208, 1997.

Back to previous Home Page at AOL (Till October 31 2008)
Back to previous Home Page at geocities.jp web host (Till March 31 2019)
Back to New Home Page (Translocated Sakura server)
-----------
Copyright 1997, Akio Hasegawa, and partly Blackwell Science and Taylor & Francis
version 1.00 2008/10/06
-----------
Please send your comment to DrHASEGAWA@aol.com